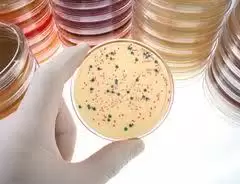
Martwicze zapalenie powięzi

Opryszczkowe zapalenie jamy ustnej, dziąseł i gardła (gingivostomatitis et pharyngitis herpetica) to najczęstsza postać pierwotnego zakażenia wirusem opryszczki typu 1 (HSV 1). Wirus ten charakteryzuje się zdolnością do pozostania w komórkach gospodarza w formie utajonej, które w określonych sytuacjach może wywoływać nawrót zakażenia. Miejscem utajenia wirusa HSV są zwoje czuciowe nerwów unerwiających miejsce początkowej infekcji.
Terminu opryszczka (ang.herpes) jako pierwszy użył Hipokrates ponad 25 wieków temu, a infekcję tę uważano za mającą niewielkie znaczenie w porównaniu z owrzodzeniami wywołanymi przez kiłę.
Opryszczka błony śluzowej jamy ustnej i gardła – przyczyny
Do pierwszego zetknięcia się z wirusem HSV-1 najczęściej dochodzi przed upływem 5 roku życia, a większość dorosłych po 30 roku życia ma swoiste przeciwciała anty-HSV 1.
Zapalenie gardła i migdałków podniebiennych występuje częściej u dorosłych i w większości przypadków wywoływane jest przez typ 1 wirusa opryszczki (HSV-1), choć przypadki choroby wywołanej przez typ 2 wirusa (HSV-2) też są możliwe. W konsekwencji wystąpienia drugiego typu wypryski opryszczkowe występują również na narządach płciowych.
W przypadku zachorowania na opryszczkę błony śluzowej jamy ustnej oraz gardła w większości przypadków choroba rozpoczyna się objawami grypopodobnymi. Chorzy skarżą się na bóle głowy, gardła i mięśni, złe samopoczucie i gorączkę. Następnie pojawiają się pęcherzyki umiejscowione na tylnej ścianie gardła i migdałkach. Pęcherzyki szybko pękają tworząc owrzodzenia. Sporadycznie pojawia się wyprysk opryszczkowy na wargach. U ok. 30% pacjentów z pierwotnym zakażeniem HSV-2 dochodzi do zapalenia opon mózgowo-rdzeniowych o łagodnym przebiegu.
W przebiegu zachorowania na opryszczkę wargową wywołaną typem 1 wirusa rozwija się odporność nabyta, która zmniejsza ryzyko wystąpienia objawowego zakażenia narządów płciowych wirusami oby typów. Nie wiadomo dokładnie, jaki jest mechanizm ochronnego działania zakażenia HSV-1 wobec późniejszych zakażeń HSV-2.
Opryszczka błony śluzowej jamy ustnej i gardła – objawy
Wśród objawów opryszczki błony śluzowej jamy ustnej oraz gardła wymienia się w szczególności:
– złe samopoczucie,
– wysoka gorączka,
– charakterystyczne wodniste pęcherzyki,
– silne zaczerwienienie miejsc zmienionych chorobowo,
– ślinotok,
– nieprzyjemny, zgorzelowy zapach z ust,
– krwawienia,
– perforacja z tworzeniem przetok tchawiczno-przełykowych,
– wyczuwalny ból przy przełykaniu,
– nudnościam,
– torsje,
– ból za mostkiem.
Opryszczka błony śluzowej jamy ustnej i gardła – leczenie
W przypadku wystąpienia niepokojących objawów należy niezwłocznie zgłosić się do lekarza, który zaplanuje diagnostykę. W celu dokładne go określenia przyczyn i rodzaju choroby specjalista powinien zlecić wykonanie badania endoskopowego przełyku z pobraniem wycinków. Ocenie poddany zostaje wygląd charakterystycznych zmian w obrębie jamy nosowo-gardłowej, oka, skóry lub narządów płciowych.
Zaleca się także wykonanie badania immunofluorescenjcyjnych komórek. Pozwala to na pobranie próbki z występujących zmian i wykorzystania przeciwciał specyficznych dla białek antygenowych wirusa. Jeżeli w materiale klinicznym znajdują się cząstki wirusa pod mikroskopem widoczne będzie świecenie fluorescencyjne.
Badaniach serologicznych pozwalających na wykrycie przeciwciał IgM w celu potwierdzenia pierwotnego zakażenia wirusem HSV. Przeciwciała klasy IgM utrzymują się we krwi stosunkowo krotki (6-8 tygodni od zakażenia). Podstawą potwierdzenia diagnozy jest stwierdzenie wzrostu miana przeciwciał IgG pomiędzy dwoma kolejnymi pobraniami.
Leczenie opryszczki jest uwarunkowane w zależności od tego które miejsce zostało zainfekowane. Inaczej przebiega leczenie opryszki wargowej, inaczej ocznej a jeszcze inaczej opryszczki narządów płciowych.
W przypadku opryszczki wargowej i zmian skórnych stosuje się maści zawierające acyklowir. Lek należy zacząć aplikować jak najwcześniej i stosunkowo często smarować miejsce zmienione chorobowo. Im wcześniej rozpoczęte leczenie tym większa szansa iż choroba nie rozwinie się do bardzo dużych rozmiarów.
W zakażeniach narządów płciowych stosuje się acyklowir w tabletkach doustnych zażywanych na ogół 5 razy dziennie przez 5 dni.
Wirus opryszczki jest szczególnie niebezpieczny wśród małych dzieci i kobiet w ciąży dlatego też w cięższych zakażeniach w obrębie centralnego układu nerwowego i u noworodków stosuje się leczenie szpitalne, gdzie lek podawany jest dożylnie przez 2-3 tygodnie.
 Niestety pomimo licznych badań i prób obecnie nie ma szczepionek przeciwko wirusowi HSV. Niemniej jednak skuteczną metodą przeciwdziałania wirusowi jest profilaktyka i eliminowanie zagrożeń zbliżających nas do kontaktów z wirusem. Wśród metod tych wymienia się miedzy innymi:
Niestety pomimo licznych badań i prób obecnie nie ma szczepionek przeciwko wirusowi HSV. Niemniej jednak skuteczną metodą przeciwdziałania wirusowi jest profilaktyka i eliminowanie zagrożeń zbliżających nas do kontaktów z wirusem. Wśród metod tych wymienia się miedzy innymi:
– eliminowanie kontaktów z osobą zakażoną,
– przestrzeganie zasad higieny osobistej,
– stosowanie prezerwatywy,
– niepalenie papierosów,
– unikanie stresu,
– odpowiednio zbilansowana dieta,
– zwiększanie odporności.
Wśród domowych metod wali z opryszczką wymienia się:
– krótkotrwałe okłady z plasterka czosnku,
– stosowanie cebuli w celach leczniczych,
– stosowanie soku z aloesu,
– okłady z olejka z drzewa herbacianego,
– okłady z bazylii.
Jak dotąd nie ma leczenia, które można całkowicie usunąć wirusa opryszczki z organizmu. Podawanie leków przeciwwirusowych ma na celu złagodzenie i skrócenie trwania objawów choroby oraz zmniejszenie prawdopodobieństwo zakażenia osób trzecich.